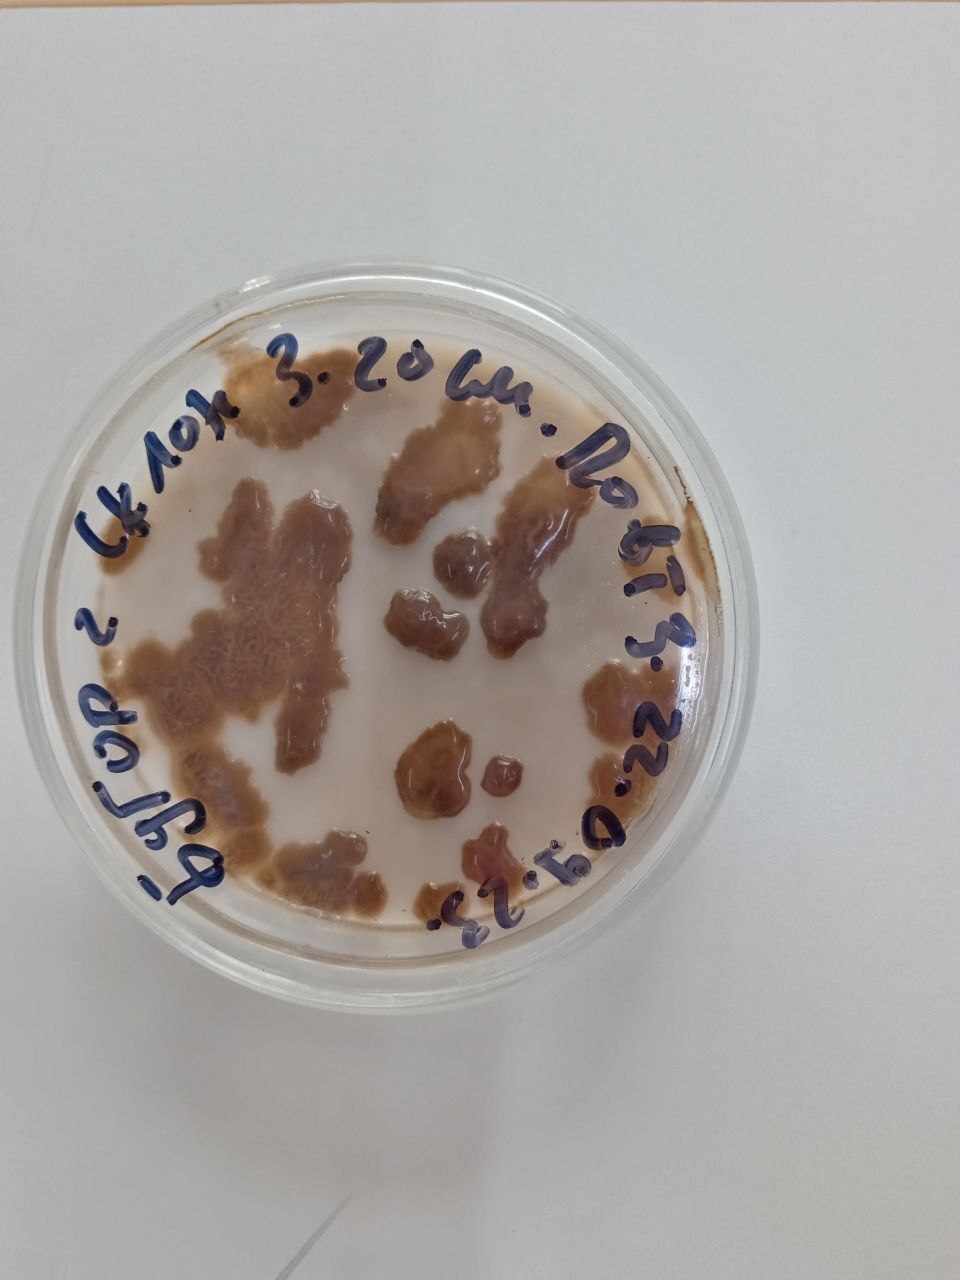
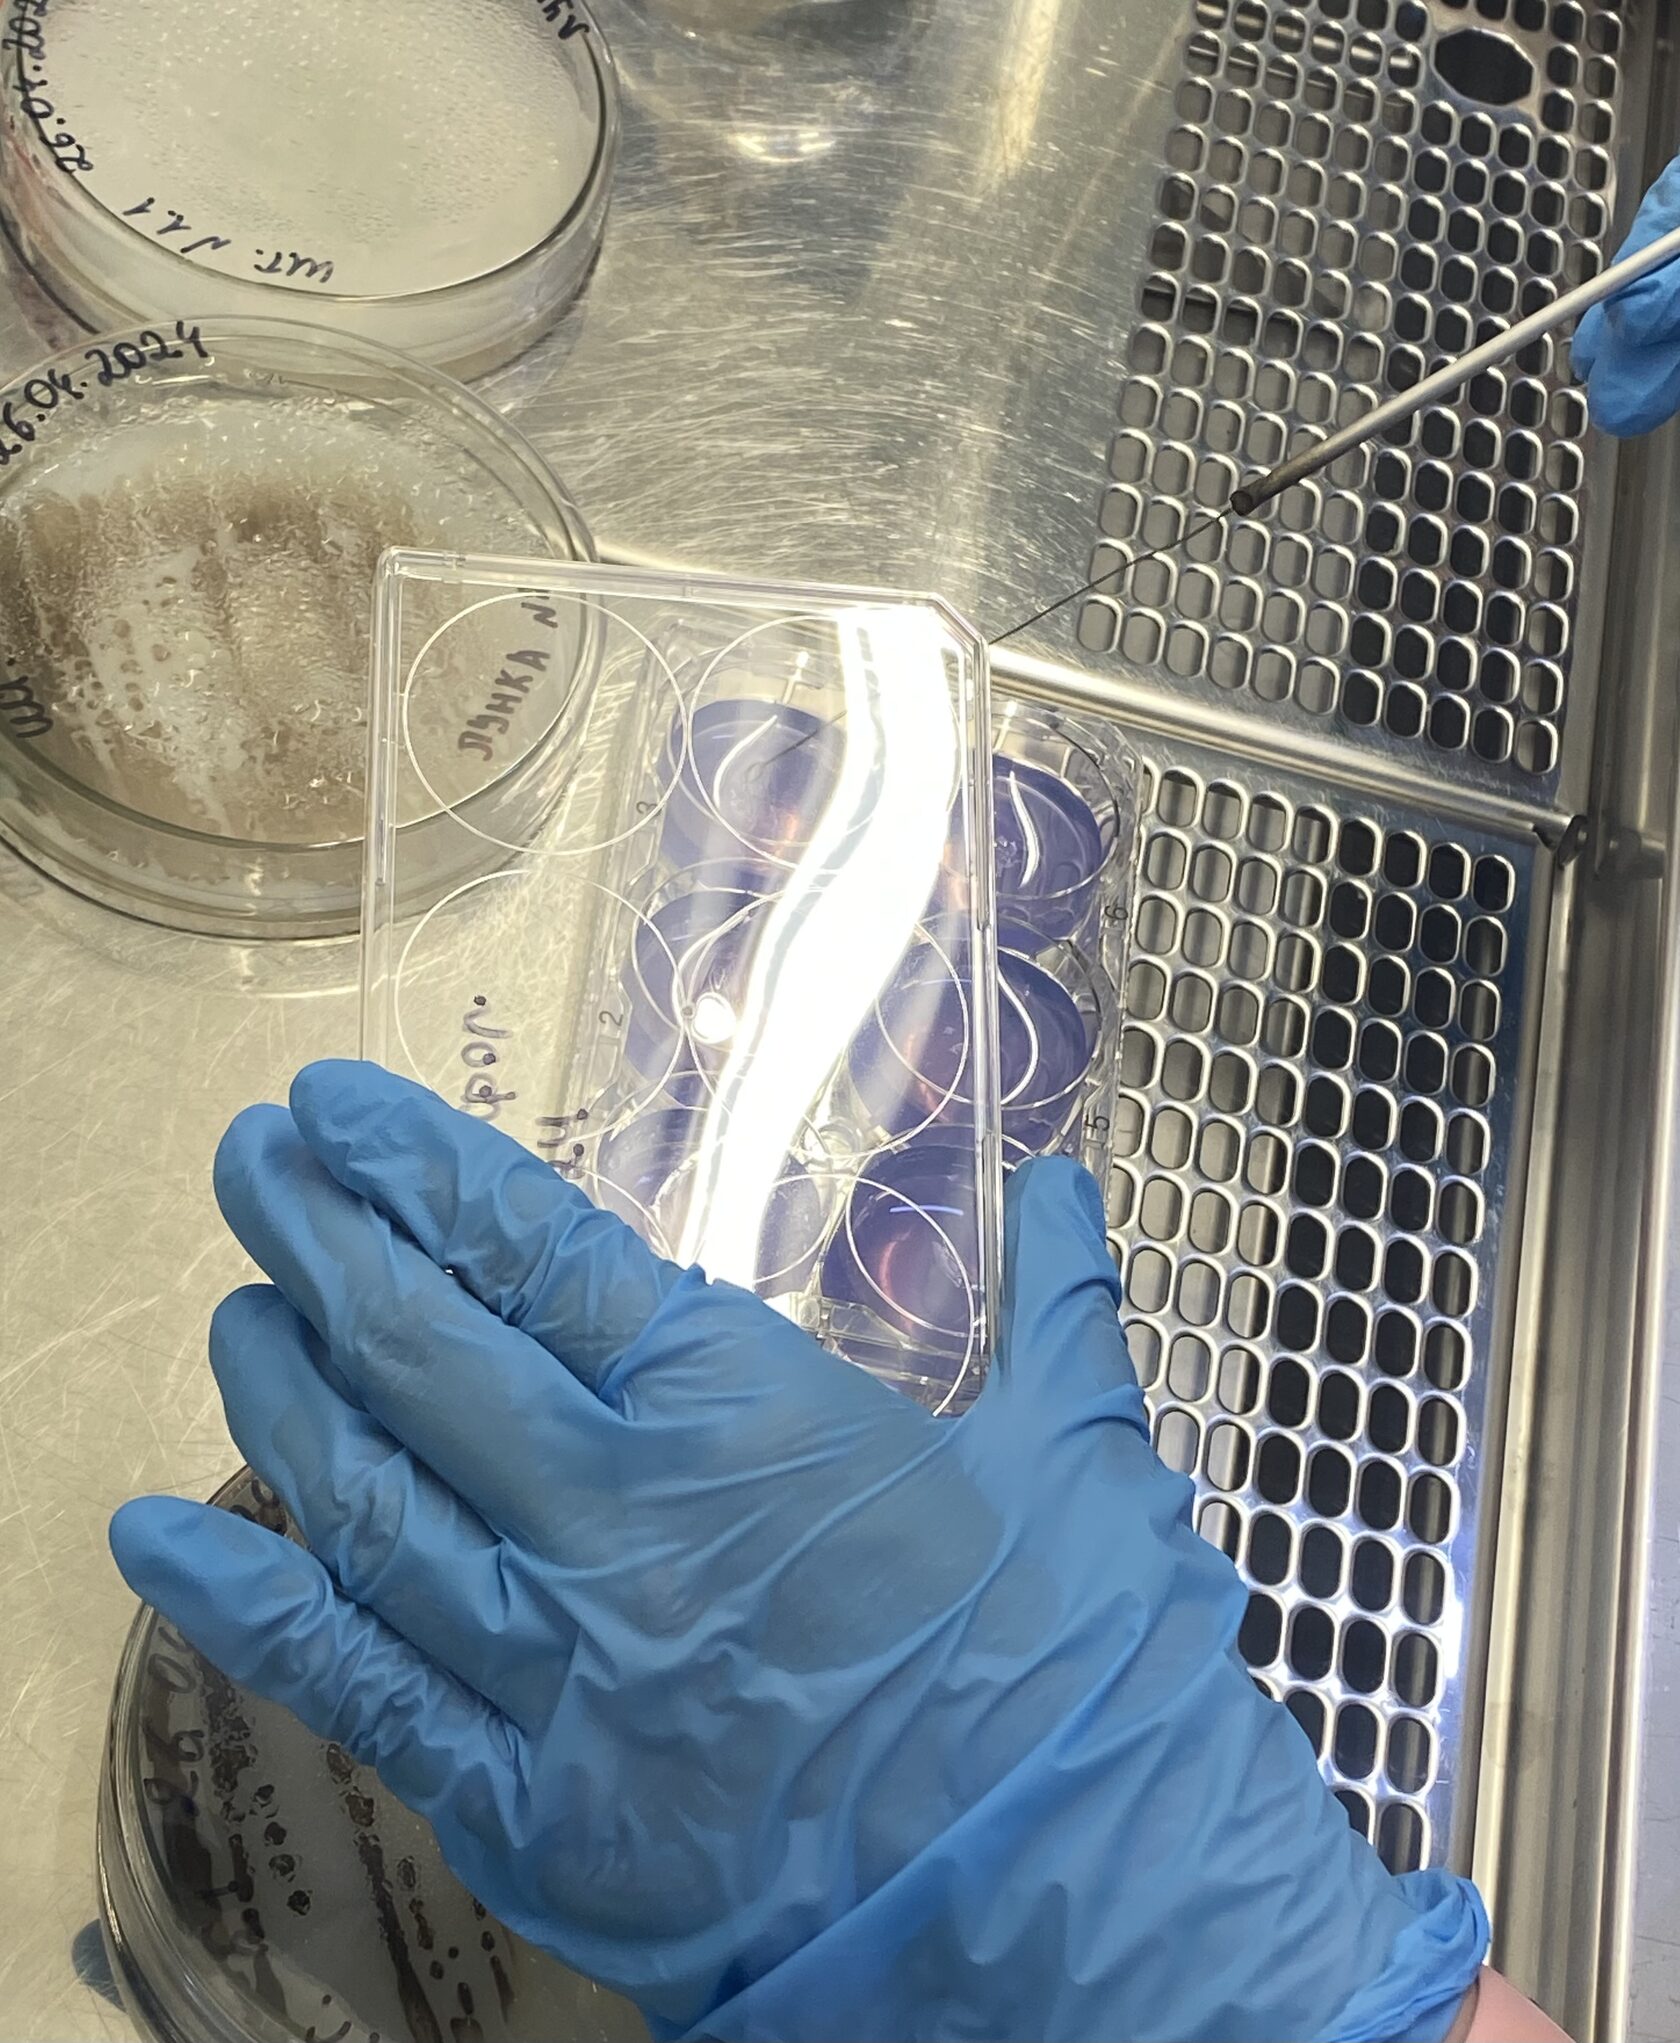

Тетерятникова Мария Сергеевна
Астраханская область, 15 лет

Разработка экологичного микробиологического препарата для повышения плодородия почв на основе азотфиксирующих бактерий бугров Бэра
Проект посвящен исследованию биологических свойств азотфиксирующих бактерий, выделенных с почв бугров Бэра Прикаспийской низменности, их способности к синтезу биологически активных веществ и стимулированию роста и развития двудольных растений. Конечным продуктом проекта будет являться микробиологическое удобрение на основе выделенных штаммов азотфиксирующих бактерий. Одними из преимуществ данного удобрения является его экологичность и возможность эффективного применения в различных почвенно-климатических условиях (засоленные почвы, засушливый климат).
В Астраханской области находятся такие уникальные геоморфологические образования, как бугры Бэра. Но к сожалению, более 80% этих бугров уже разрушены, что делает их исследование особенно важным для сохранения и понимания их уникальной экосистемы. Несмотря на экстремальные условия окружающей среды, такие как низкая влажность, высокая засоленность почв и высокие температуры, на них произрастает более 150 видов растений, включая эндемичные виды. Это натолкнуло меня на гипотезу, что решением проблемы низкого плодородия почв нашего региона в условиях экстремальных климатических условий могут стать почвенные бактерии, в том числе азотфиксирующие. Поэтому целью моего проекта стало изучение свойств и фитостимулирующей активности азотфиксирующих бактерий, выделенных из почв бугров Бэра, с целью создания биопрепарата нового поколения.